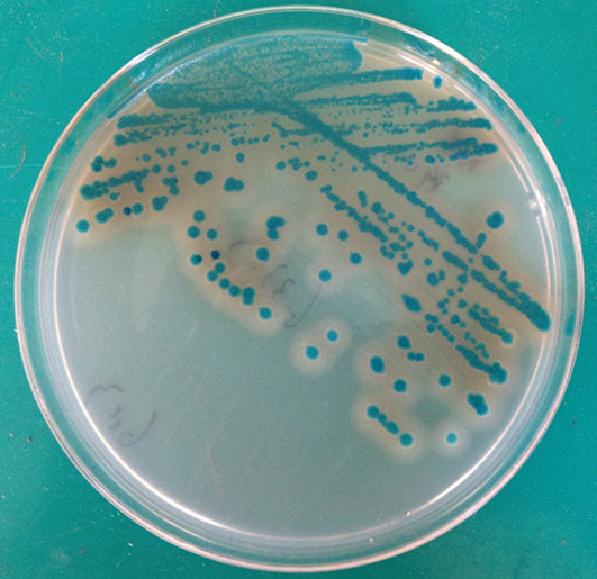

海博微信公众号
海博微信公众号
 海博天猫旗舰店
海博天猫旗舰店


 海博微信公众号
海博微信公众号
 海博天猫旗舰店
海博天猫旗舰店


新代蜡样芽胞杆菌显色培养基(第三代)发布!改进型显色剂和添加剂,与前代相比特异性和灵敏度明显提高。
蜡样芽孢杆菌显色培养基是青岛海博生物公司改良的培养基,用于食品、水、乳制品和肉制品中蜡样芽孢杆菌的快速检测。改进型显色剂和添加剂,特异性和灵敏度明显提高。蜡样芽孢杆菌显蓝绿色且菌落周围有一不透明环,其它菌显蓝绿色、黄色或无色,革兰氏阴性菌被抑制。
蜡样芽胞杆菌为革兰氏阳性芽胞杆菌。蜡样芽胞杆菌可引起食物中毒等食源性疾病。为了在食品中有效开展蜡样芽胞杆菌检测,以保障食品安全,降低蜡样芽胞杆菌感染的风险, 防止食源性蜡样芽胞杆菌疾病的发生,我国早在1984年制定了《食品卫生微生物学检验 蜡样芽胞杆菌检验》(GB/T 4789.14-1988)标准。现行标准为GB/T 4789.14-2003
上一篇:海博网站开通质控报告查询功能
下一篇:海博新产品:冻干兔血浆上市!



